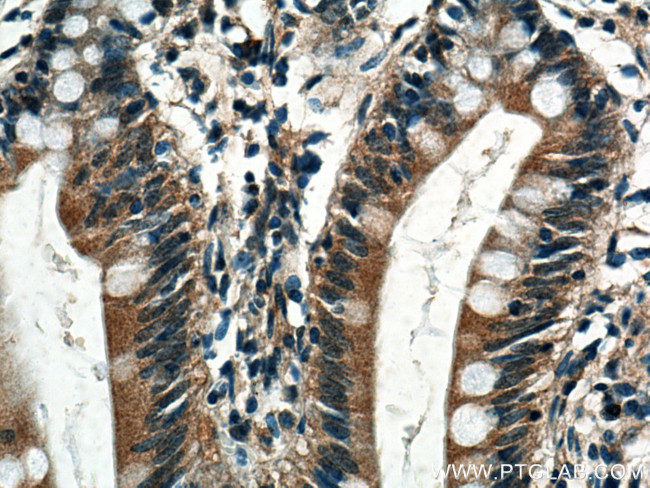
TRPM5 Antibody in Immunohistochemistry (Paraffin) (IHC (P))

Search
Proteintech
TRPM5 Polyclonal Antibody
{{$productOrderCtrl.translations['antibody.pdp.commerceCard.promotion.promotions']}}
{{$productOrderCtrl.translations['antibody.pdp.commerceCard.promotion.viewpromo']}}
{{$productOrderCtrl.translations['antibody.pdp.commerceCard.promotion.promocode']}}: {{promo.promoCode}} {{promo.promoTitle}} {{promo.promoDescription}}. {{$productOrderCtrl.translations['antibody.pdp.commerceCard.promotion.learnmore']}}
产品信息
18027-1-AP
种属反应
宿主/亚型
分类
类型
抗原
偶联物
形式
浓度
规格
纯化类型
保存液
内含物
保存条件
运输条件
产品详细信息
Immunogen sequence: MQDVQGPRP GSPGDAEDRR ELGLHRGEVN FGGSGKKRGK FVRVPSGVAP SVLFDLLLAE WHLPAPNLVV SLVGEEQPFA MKSWLRDVLR KGLVKAAQST GAWILTSALR VGLARHVGQA VRDHSLASTS TKVRVVAVGM ASLGRVLHRR ILEEAQEDFP VHYPEDDGGS QGPLCSLDSN LSHFILVEPG PPGKGDGLTE LRLRLEKHIS EQRAGYGGTG SIEIPVLCLL VNGDPNTLER ISRAVEQAAP WLILAGSGGI ADVLAALVNQ PHLLVPKVAE KQFKEKFPSK HFSWEDIVRW TKLLQNITSH QHLLTVYDFE QEGSEELDTV ILKALVKACK SHSQEPQDYL D (1-350 aa encoded by BC093787)
靶标信息
This gene encodes a member of the transient receptor potential protein family, which is a diverse group of proteins with structural features typical of ion channels. This protein plays an important role in taste transduction, and has characteristics of a calcium-activated, non-selective cation channel that carries Na+, K+, and Cs+ ions equally well, but not Caions. It is activated by lower concentrations of intracellular Ca, and inhibited by higher concentrations. It is also a highly temperature-sensitive, heat activated channel showing a steep increase of inward currents at temperatures between 15 and 35 degrees Celsius. This gene is located within the Beckwith-Wiedemann syndrome critical region-1 on chromosome 11p15. 5, and has been shown to be imprinted, with exclusive expression from the paternal allele.
仅用于科研。不用于诊断过程。未经明确授权不得转售。
生物信息学
蛋白别名: Long transient receptor potential channel 5; long transient receptor potential-related channel 5; LTrpC-5; MLSN1 and TRP-related; MLSN1 and TRP-related putative protein; MLSN1- and TRP-related gene 1 protein; Transient receptor potential cation channel subfamily M member 5; trpm5
基因别名: 9430099A16Rik; LTrpC-5; LTRPC5; MTR1; TRPM5
UniProt ID: (Human) Q9NZQ8, (Mouse) Q9JJH7
Entrez Gene ID: (Human) 29850, (Mouse) 56843, (Rat) 365391